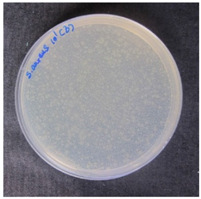
Coatings 07 00145 i006
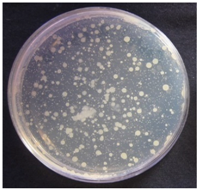
Coatings 07 00145 i009

In Vitro Assessment of Sericin-Silver Functionalized Silk Fabrics for Enhanced UV Protection and Antibacterial Properties Using Experimental Design
Abstract
:1. Introduction
2. Experimental
2.1. Materials and Chemicals
2.2. Preparation of SS Solution
2.3. Functionalization of Silk Fabrics by SS-AgNP Bio-Nanocomposites
2.4. Experimental Design and Data Analysis
2.5. Characterization of SS-AgNP Bio-Nanocomposites
2.6. Color Measurement
2.7. Contact Angle Measurement
2.8. Determination of Ultraviolet Protection Factor (AS/NZS 4399:1996)
2.9. Antimicrobial Activity Test (AATCC Test Method 100-1999)
2.10. Washing Fastness (AATCC Test Method 61-1996)
2.11. The Ag+ Ion Release Profile
2.12. Cytotoxicity Test (MTT Assay/ISO 10993 Standard [28])
3. Results and Discussion
3.1. Optimization of SS-AgNP Bio-Nanocomposites by RSM
3.2. Characterization of SS-AgNP and Functionalized Silk Fabrics
3.3. Color Coordinates
3.4. Contact Angle
3.5. Evaluation of UV Protection Property
3.6. Antibacterial Activity of SS-AgNP Finished Silks
3.7. Washing Fastness
3.8. Cytotoxicity Test
4. Conclusions
Supplementary Materials
Acknowledgments
Author Contributions
Conflicts of Interest
References
- Van der Rhee, H.J.; De Vries, E.; Coebergh, J.W. Regular sun exposure benefits health. Med. Hypotheses 2016, 97, 34–37. [Google Scholar] [CrossRef] [PubMed]
- Yu, Y.; Hurren, C.; Millington, K.R.; Sun, L.; Wang, X. Understanding the influence of fibre, yarn and fabric parameters on UV protection of wool-knitted fabrics. J. Text. Inst. 2017, 108, 1609–1617. [Google Scholar] [CrossRef]
- Lu, H.; Fei, B.; Xin, J.H.; Wang, R.; Li, L. Fabrication of UV blocking nanohybrid coating via miniemulsion polymerisation. J. Colloid Interface Sci. 2006, 300, 111–116. [Google Scholar] [CrossRef] [PubMed]
- Gowri, S.; Almeida, L.; Amorim, T.; Carneiro, N.; Souto, A.P.; Esteves, M.F. Polymer nanocomposites for multifunctional finishing of textiles—A review. Text. Res. J. 2010, 80, 1290–1306. [Google Scholar] [CrossRef]
- Nussbaumer, R.J.; Caseri, R.; Smith, P.; Tervoort, T.A. Pol-ymer TiO2 nanocomposites: A route towards visually trans-parent broadband UV filters and high refractive index materials. Macromol. Mater. Eng. 2003, 288, 44–49. [Google Scholar] [CrossRef]
- Pisitsak, P.; Hutakamol, J.; Jeenapak, S.; Wanmanee, P.; Nuammaiphum, J.; Thongcharoen, R. Natural dyeing of cotton with xylocarpus granatum bark extract: Dyeing, fastness, and ultraviolet protection properties. Fibers Polym. 2016, 17, 560–568. [Google Scholar] [CrossRef]
- Mongkholrattanasit, R.; Punrattanasin, N.; Rungruangkitkrai, N.; Somboon, B.; Narumol, N.; Nakpathom, M. Dyeing, fastness and UV protection properties of cotton fabric dyed with mangrove bark extract. Cell. Chem. Technol. 2016, 50, 163–171. [Google Scholar]
- Cho, K.Y.; Moon, J.Y.; Lee, Y.W.; Lee, K.G.; Yeo, J.H.; Kweon, H.Y.; Kim, K.H.; Cho, C.S. Preparation of self-assembled silk sericin nanoparticles. Int. J. Biol. Macromol. 2003, 32, 36–42. [Google Scholar] [CrossRef]
- Doakhan, S.; Montazer, M.; Rashidi, A.; Moniri, R.; Moghadam, M.B. Influence of sericin/TiO2 nanocomposite on cotton fabric: Part 1. Enhanced antibacterial effect. Carbohydr. Polym. 2013, 94, 737–748. [Google Scholar] [CrossRef] [PubMed]
- Aramwit, P.; Damrongsakkul, S.; Kanokpanont, S.; Srichana, T. Properties and anti-tyrosinase activity of sericin from various extraction methods. Biotechnol. Appl. Biochem. 2010, 55, 91–98. [Google Scholar] [CrossRef] [PubMed]
- Mondal, M.; Trivedy, K.; Kumar, S.N. The silk proteins, sericin and fibroin in silkworm, Bombyx mori Linn.—A review. Casp. J. Environ. Sci. 2007, 5, 63–76. [Google Scholar]
- Zhaorigetu, S.; Yanaka, N.; Sasaki, M.; Watanabe, H.; Kato, N. Inhibitory effects of silk protein, sericin on UVB-induced acute damage and tumor promotion by reducing oxidative stress in the skin of hairless mouse. J. Photochem. Photobiol. B 2003, 71, 11–17. [Google Scholar] [CrossRef]
- Zhang, Y.Q. Applications of natural silk protein sericin in biomaterials. Biotechnol. Adv. 2002, 20, 91–100. [Google Scholar] [CrossRef]
- Kundu, S.C.; Dash, B.C.; Dash, R.; Kaplan, D.L. Natural protective glue proteins, sericin bioengineered by silkworms: Potential for biomedical and biotechnological applications. Prog. Polym. Sci. 2008, 33, 998–1012. [Google Scholar] [CrossRef]
- Fabiani, C.; Pizzichini, M.; Spadoni, M.; Zeddita, G. Treatment of waste water from silk degumming processes for protein recovery and water reuse. Desalination 1996, 105, 1–9. [Google Scholar] [CrossRef]
- Drader, M.; Aranda, P.; Ruiz-Hitzky, E. Bionanocomposites: A new concept of ecological, bioinspired, and functional hybrid materials. Adv. Mater. 2007, 19, 1309–1319. [Google Scholar] [CrossRef]
- Mangiacapra, P.; Gorrasi, G.; Sorrentino, A.; Vittoria, V. Biodegradable nanocomposites obtained by ball milling of pectin and montmorillonites. Carbohydr. Polym. 2006, 64, 516–523. [Google Scholar] [CrossRef]
- Liu, S.; He, J.; Xue, J.; Ding, W. Efficient fabrication of transparent antimicrobial poly(vinyl alcohol) thin film. J. Nanopart. Res. 2009, 11, 553–560. [Google Scholar] [CrossRef]
- Wattanodorn, Y.; Jenkana, R.; Atorngitjawatd, P.; Wirasate, S. Antibacterial anionic waterborne polyurethanes/Ag nanocomposites with enhanced mechanical properties. Polym. Test. 2014, 40, 163–169. [Google Scholar] [CrossRef]
- Lu, Z.; Xiao, J.; Wang, Y.; Meng, M. In Situ synthesis of silver nanoparticles uniformly distributed on polydopamine-coated silk fibers for antibacterial application. J. Colloid Interface Sci. 2015, 452, 8–14. [Google Scholar] [CrossRef] [PubMed]
- Aramwit, P.; Bang, N.; Ratanavaraporn, J.; Ekgasit, S. Green synthesis of silk sericin-capped silver nanoparticles and their potent anti-bacterial activity. Nanoscale Res. Lett. 2014, 9, 79. [Google Scholar] [CrossRef] [PubMed]
- Selvakannan, P.R.; Swami, A.; Srisathiyanarayanan, D.; Shirude, P.S.; Pasricha, R.; Mandale, A.B.; Sastry, M. Synthesis of aqueous Au core–Ag shell nanoparticles using tyrosine as a pH-dependent reducing agent and assembling phase-transferred silver nanoparticles at the air-water interface. Langmuir 2004, 20, 7825–7836. [Google Scholar] [CrossRef] [PubMed]
- Aramwit, P.; Kanokpanont, S.; Nakpheng, T.; Srichana, T. The effect of sericin from various extraction methods on cell viability and collagen production. Int. J. Mol. Sci. 2010, 11, 2200–2211. [Google Scholar] [CrossRef] [PubMed]
- Box, G.E.P.; Wilson, K.B. On the experimental attainment of optimum conditions. J. R. Stat. Soc. Ser. B 1951, 13, 1–45. [Google Scholar]
- AS/NZS 4399:1966 Standard Test Method for Sun Protective Clothing Evaluation and Classification; Standards Australian: Homebush, Australia; Standards New Zealand: Wellington, New Zealand, 1996.
- AATCC 100-1999 Standard Test Method for Assessment of Antibacterial Finishes on Textile Materials; American Association of Textile Chemists and Colorists technical manual; American Association of Textile Chemists and Colorists (AATCC): Research Triangle Park, NC, USA, 1999.
- AATCC 61-1996 Standard Test Method for Color Fastness to Laundering, Home and Commercial: Accelerated; American Association of Textile Chemists and Colorists (AATCC): Research Triangle Park, NC, USA, 1996.
- ISO 10993-5 Standard Test Method for Biological Evaluation of Medical Devices—Part 5: Tests for In Vitro Cytotoxicity; International Organization for Standardization (ISO): Geneva, Switzerland, 2009.
- Zhang, G.; Liu, Y.; Gao, X.; Chen, Y. Synthesis of silver nanoparticles and antibacterial property of silk fabrics treated by silver nanoparticles. Nanoscale Res. Lett. 2014, 9, 216–224. [Google Scholar] [CrossRef] [PubMed]
- Das, R.; Gang, S.; Nath, S.S. Preparation and antibacterial activity of silver nanoparticles. J. Biomater. Nanobiotechnol. 2011, 2, 472–475. [Google Scholar] [CrossRef]
- Li, W.R.; Xie, X.B.; Shi, Q.S.; Zeng, H.Y.; Ou-Yang, Y.S.; Chen, Y.B. Antibacterial activity and mechanism of silver nanoparticles on Escherichia coli. Appl. Microbiol. Biotechnol. 2010, 85, 1115–1122. [Google Scholar] [CrossRef] [PubMed]
- Chao, L.; Xiansong, W.; Feng, C.; Chunlei, Z.; Xiao, Z.; Kan, W.; Xiangcui, D. The antifungal activity of graphene oxide–silver nanocomposites. Biomaterials 2013, 34, 3882–3890. [Google Scholar]
- Andiappan, M.; Kumari, T.; Sundaramoorthy, S.; Meiyazhagan, G.; Manoharan, P.; Venkataraman, G. Comparison of eri and tasar silk fibroin scaffolds for biomedical applications. Prog. Biomater. 2016, 5, 81–91. [Google Scholar] [CrossRef] [PubMed]
- Lu, Q.; Hu, X.; Wang, X.; Kluge, J.A.; Lu, S.; Cebe, P.; Kaplan, D.L. Water-insoluble silk films with silk I structure. Acta Biomater. 2010, 6, 1380–1387. [Google Scholar] [CrossRef] [PubMed]
- Qu, R.; Gao, J.; Tang, B.; Ma, Q.; Qu, B.; Sun, C. Preparation and property of polyurethane/nanosilver complex fibers. Appl. Surf. Sci. 2014, 294, 81–88. [Google Scholar] [CrossRef]
- Kaspar, T.C.; Drouday, T.; Chambers, S.A.; Bagus, P.S. Spectroscopic evidence for Ag (III) in highly oxidized silver films by X-ray photoelectron spectroscopy. J. Phys. Chem. C 2010, 114, 21562–21571. [Google Scholar] [CrossRef]
- Yue, X.; Lin, H.; Yan, T.; Zhang, D.; Lin, H.; Chen, Y. Synthesis of silver nanoparticles with sericin and functional finishing to cotton fabrics. Fibers Polym. 2014, 15, 716–722. [Google Scholar] [CrossRef]
- Kan, C.; Lam, Y. The effect of plasma treatment on water absorption properties of silk fabrics. Fibers Polym. 2015, 16, 1705–1714. [Google Scholar] [CrossRef]
- Chen, F.; Liu, X.; Yang, H.; Dong, B.; Zhou, Y.; Chen, D.; Hu, H.; Xiao, X.; Fan, D.; Zhang, C. A simple one-step approach to fabrication of highly hydrophobic silk fabrics. Appl. Surf. Sci. 2016, 360, 207–212. [Google Scholar] [CrossRef]
- Becker, M.A.; Willman, P.; Tuross, N.C. The US first ladies gowns: A biochemical study of silk preservation. J. Am. Inst. Conserv. 1995, 34, 141–152. [Google Scholar] [CrossRef]
- Reinert, G.; Fuso, F.; Hilfiker, R.; Schmidt, E. UV-protecting properties of textile fabrics and their improvement. Text. Chem. Color. 1997, 29, 36–43. [Google Scholar]
- Lu, Z.S.; Meng, M.; Jiang, Y.; Xie, J. UV-assisted in situ synthesis of silver nanoparticles on silk fibers for antibacterial applications. Colloids Surf. A 2014, 447, 1–7. [Google Scholar] [CrossRef]
- Brett, D.W. A discussion of silver as an antimicrobial agent: Alleviating the confusion. Ostomy/Wound Manag. 2006, 52, 34–41. [Google Scholar]









| Variable | Symbol | Coded Levels | ||||
|---|---|---|---|---|---|---|
| −α | −1 | 0 | 1 | α | ||
| AgNO3 (ppm) | X1 | 896.5 | 1000 | 1250 | 1500 | 1603.5 |
| Silk sericin (SS) (ppm) | X2 | 6465 | 7500 | 10,000 | 12,500 | 13,535 |
| No. | Variable | Response Y1 UV Protection Factor (UPF) | Response Y2 (%reduction of E. coli) | Response Y3 (%reduction of S. aureus) | ||||
|---|---|---|---|---|---|---|---|---|
| X1 | X2 | Actual | Predicted | Actual | Predicted | Actual | Predicted | |
| 1 | 7500 | 1000 | 33.7 | 29.5 | 91.2 | 87.7 | 80.3 | 73.5 |
| 2 | 12,500 | 1000 | 47.1 | 43.6 | 69.5 | 71.0 | 59.8 | 55.8 |
| 3 | 7500 | 1500 | 35.6 | 33.4 | 95.7 | 93.8 | 89.4 | 85.4 |
| 4 | 12,500 | 1500 | 49.3 | 46.9 | 74.7 | 78.1 | 66.4 | 66.7 |
| 5 | 10,000 | 896.5 | 38.1 | 36.8 | 88.3 | 89.2 | 77.2 | 75.8 |
| 6 | 10,000 | 1603.5 | 45.2 | 41.9 | 100.0 | 98.6 | 100.0 | 91.9 |
| 7 | 6465 | 1250 | 27.2 | 27.7 | 79.4 | 82.9 | 69.5 | 69.7 |
| 8 | 13,535 | 1250 | 52.1 | 47.1 | 64.2 | 60.0 | 55.8 | 43.9 |
| 9 | 10,000 | 1250 | 42.3 | 39.9 | 100.0 | 100.0 | 99.8 | 95.0 |
| 10 | 10,000 | 1250 | 42.0 | 39.9 | 99.8 | 100.0 | 100.0 | 95.0 |
| 11 | 10,000 | 1250 | 42.6 | 39.9 | 100.0 | 100.0 | 98.7 | 95.0 |
| 12 | 10,000 | 1250 | 42.7 | 39.9 | 100.0 | 100.0 | 100.0 | 95.0 |
| 13 | 10,000 | 1250 | 42.3 | 39.9 | 100.0 | 100.0 | 100.0 | 95.0 |
| 14 | 10,000 | 1250 | 42.8 | 39.9 | 100.0 | 100.0 | 99.6 | 95.0 |
| SS Content (ppm) | AgNO3 Content (ppm) | Size (nm) | UPF | %reduction of E. coli | %reduction of S. aureus |
|---|---|---|---|---|---|
| 9800 | 1300 | 39.4 ± 8.6 | 40.0 | 100.0 | 97.9 |
| Samples | L* | a* | b* | ΔE* | Fabric Images |
|---|---|---|---|---|---|
| untreated | 90.89 | 4.23 | −7.36 | – |  |
| treated | 69.24 | 5.78 | −3.25 | 22.09 |  |
| Untreated Silk | SS-Treated Silk | SS-AgNP Treated Silk |
|---|---|---|
 |  |  |
| 12.28° ± 3.7 | 35.15° ± 2.3 | 41.23° ± 3.8 |
| Samples | S. aureus | E. coli |
|---|---|---|
| Untreated silk | |  |
| SS treated silk |  | |
| SS-AgNP treated silk |  |  |
| Samples | Washing Times | UPF | %reduction | |
|---|---|---|---|---|
| S. aureus | E. coli | |||
| Untreated | – | 5.1 | – | – |
| Finished | 0 | 42.8 | 99.3 | 100.0 |
| 10 | 39.4 | 93.5 | 95.4 | |
| 20 | 35.6 | 88.5 | 90.2 | |
| No. | Sample | Before Dyed (×200) | After Dyed (×200) |
|---|---|---|---|
| 1 | Negative control |  |  |
| 2 | Positive control |  |  |
| 3 | Untreated silk |  |  |
| 4 | Treated silk |  |  |
© 2017 by the authors. Licensee MDPI, Basel, Switzerland. This article is an open access article distributed under the terms and conditions of the Creative Commons Attribution (CC BY) license (http://creativecommons.org/licenses/by/4.0/).
Share and Cite
Chitichotpanya, P.; Chitichotpanya, C. In Vitro Assessment of Sericin-Silver Functionalized Silk Fabrics for Enhanced UV Protection and Antibacterial Properties Using Experimental Design. Coatings 2017, 7, 145. https://doi.org/10.3390/coatings7090145
Chitichotpanya P, Chitichotpanya C. In Vitro Assessment of Sericin-Silver Functionalized Silk Fabrics for Enhanced UV Protection and Antibacterial Properties Using Experimental Design. Coatings. 2017; 7(9):145. https://doi.org/10.3390/coatings7090145
Chicago/Turabian StyleChitichotpanya, Pisutsaran, and Chayanisa Chitichotpanya. 2017. "In Vitro Assessment of Sericin-Silver Functionalized Silk Fabrics for Enhanced UV Protection and Antibacterial Properties Using Experimental Design" Coatings 7, no. 9: 145. https://doi.org/10.3390/coatings7090145
APA StyleChitichotpanya, P., & Chitichotpanya, C. (2017). In Vitro Assessment of Sericin-Silver Functionalized Silk Fabrics for Enhanced UV Protection and Antibacterial Properties Using Experimental Design. Coatings, 7(9), 145. https://doi.org/10.3390/coatings7090145




